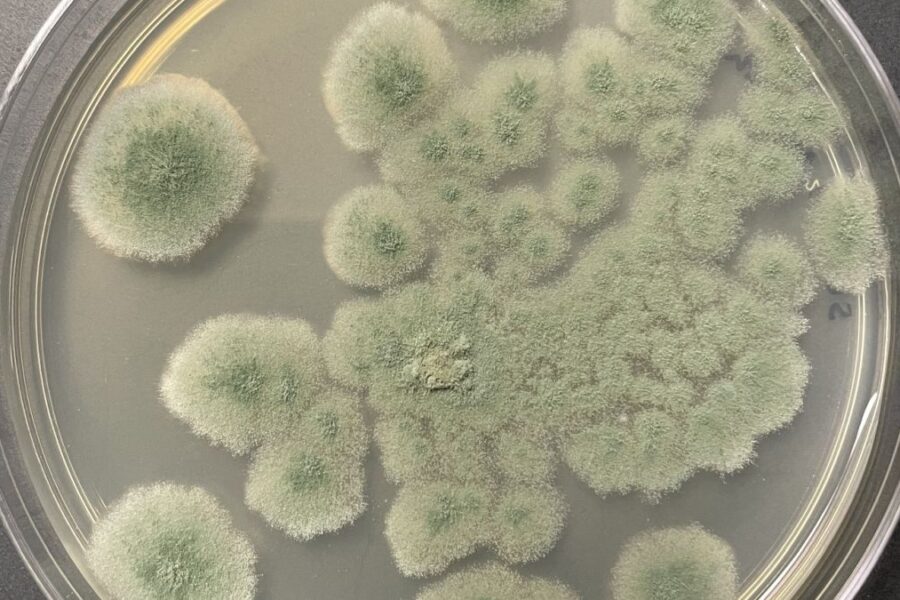
NASA Cleanroom Fungus Shows Deep-Space Staying Power, Raising New Planetary Protection Questions for Mars Missions

NASA Cleanroom Fungus Shows Deep-Space Staying Power, Raising New Planetary Protection Questions for Mars Missions
A fungus found in NASA spacecraft cleanrooms has shown an unusual ability to endure conditions that mimic deep space, renewing concerns about how easily microbes could hitch a ride to Mars.
The findings add fresh detail to a long-running challenge in planetary protection: preventing Earth life from contaminating other worlds.
In tests of organisms collected from facilities used during the Mars 2020 program, researchers identified 27 fungal strains that persisted despite routine decontamination. Many of the samples were traced to spores known as conidia, which can remain dormant and highly resilient under stress.
Why this fungus stood out?
When the team exposed cultured spores to intense ultraviolet light, low pressure consistent with Mars, and temperatures down to about -60°C, most strains showed some survival. The standout was Aspergillus calidoustus, which remained viable after multiple space-relevant stressors.
Researchers also subjected spores to radiation doses meant to approximate the ionizing radiation environment expected during a journey toward Mars.
Aspergillus calidoustus endured months of exposure in simulation, suggesting it could be among the more plausible forward contaminants if carried on spacecraft hardware.
What it means for planetary protection
The work does not indicate Mars contamination is inevitable, and the authors emphasize it is a risk-quantification study rather than evidence of active transfer.
Still, it highlights fungi as a comparatively under-studied part of contamination control, which has historically focused more on bacteria and bacterial spores.
NASA and international guidelines already set strict cleanliness requirements for Mars-bound missions, including limits on spore counts on spacecraft surfaces.
The new results suggest that controlling fungal spores may deserve more attention as agencies plan longer-duration missions and more complex hardware that is harder to sterilize fully.
A second concern: crew health
Beyond protecting other planets, certain Aspergillus species are linked to respiratory illness, including aspergillosis, particularly in vulnerable individuals. Reducing fungal contamination inside spacecraft could therefore also support astronaut health on long missions where medical care is limited.
The researchers say the goal is to help refine microbial risk assessments and improve strategies used to keep spacecraft as biologically clean as possible. The study was published in Applied and Environmental Microbiology, with implications for current and future Mars exploration planning.



